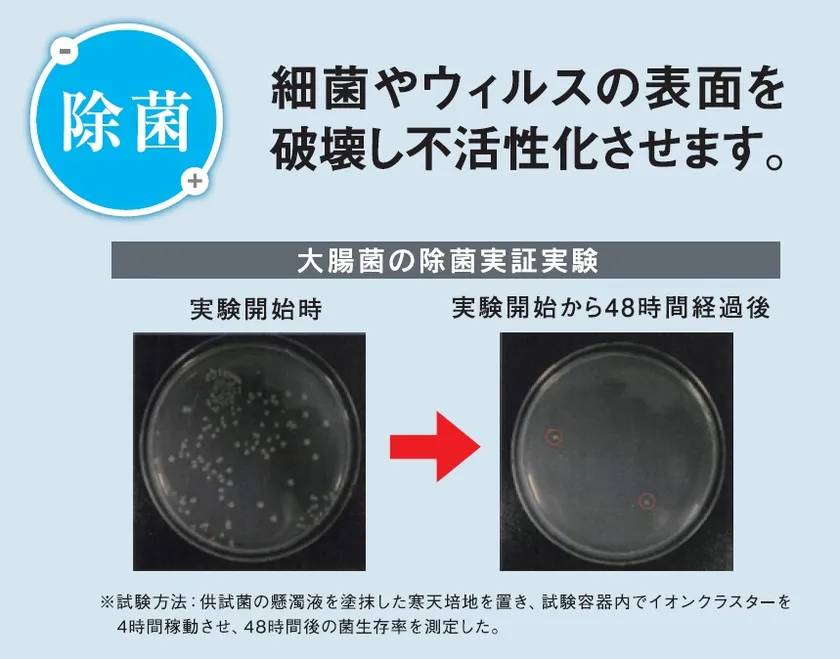

世界15か国で認められた放電技術を搭載 ウイルス対策に効果的な除菌脱臭機「イオンクラスター」を発売
株式会社キムラ(本社:北海道札幌市 代表取締役社長:木村 勇介)は、ウイルス対策に効果がある「イオンクラスター除菌脱臭装置」を搭載した24時間換気システム(ダクトインタイプ)及び、据置タイプを11月に発売しました。
放電技術で、イオンクラスターを作り出し、付着した菌やウイルス、気になる臭い対策に優れた商品として、病院や救急車、保育所等多くの施設に導入されています。
■製品概要
製品名 :イオンクラスター
製品タイプ :ダクトインタイプ/据置タイプ
販売エリア :全国
価格 :ダクトインタイプ・据置タイプともに
エンドユーザー価格 ¥250,000/台
■ダクトインタイプ販売の背景
据え置きタイプは、設置した空間に直接イオンクラスター(OHラジカル)を吹き出すため菌やニオイを除去する効果もはっきりしており、医療機関や各種施設、事務所などで広く採用されております。ダクトインタイプについては、換気システムのダクトの中でイオンクラスターが消滅するのではないかとの意見もあり、慎重な販売姿勢を取らざるを得ない状況でした。しかし、この度実際の住宅を使用した検証結果により、その効果が確認できましたので、より積極的な姿勢に転換し、広く販売を進めます。
■特徴(1) 放電技術でナノレベルの分解効力
世界15か国で認められた「パルスプラズマ放電技術」により、世界最高レベル12eVのイオン化エネルギーを発生します。マスクや空気洗浄機のHEPAフィルターを通過した浮遊物でも分解除去する、ナノレベルの分解効力があり、インフルエンザウイルス(H1N1)や大腸菌、ブドウ球菌等の除去率が実証されています。
除菌効果(大腸菌の除菌実証実験)

菌類除去率の検証結果
■特徴(2) 空気から家や人を守る
カビ対策や脱臭効果に優れている本製品はカビによる人体へのアレルギー反応の軽減や、室内の残留ニオイの軽減による爽快感があり家にも優しく、空気から家と人を守る役割を担っています。一般的にイオン発生機では、イオン発生の際にオゾンの発生があります。オゾンは人体に影響を及ぼすことが懸念されていますが、本製品から発生するオゾン量は基準値を大きく下回っており、人体への影響はございません。

カビ対策、脱臭効果の検証結果
■場所や用途に合わせて選べる2タイプ

製品写真
▼ダクトインタイプ
住宅用24時間換気システムのダクトに組み込むダクトインタイプは、より高いイオン化エネルギーを発生することが可能です。その為、イオンクラスターの残存時間がより長くなり、住宅全体にイオンクラスターを放出することが可能です。
▼据置タイプ
机上で使用可能な据置タイプは、A4(210mm×121mm×297mm)のコンパクトサイズ、1台で20帖(約33m2)分としてお使い頂けます。小型のため宅内の移動に大変便利である上、性能はほとんど変わらず、強いエネルギーを発生します。
■会社概要
社名 : 株式会社キムラ
所在地 : 北海道札幌市東区北6条東4丁目1番地7 デ・アウネさっぽろ6階
代表 : 代表取締役社長 木村 勇介
事業内容 : 住宅資材を中心とした卸売
Webサイト : https://www.kimuranet.jp/index.html
証券コード: 7461 JASDAQ














